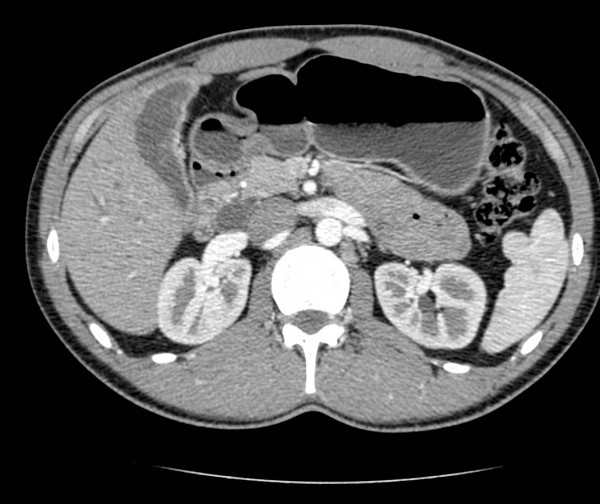

Последствия, которые могут возникнуть при перегибе желчного пузыря
При наличии перегиба желчный пузырь не может полноценно выполнять свою работу. Возникает застой желчи в желчном пузыре, что создает условия для возникновения различных заболеваний (холецистита, желчнокаменной болезни, полип стенки желчного пузыря и т.п.), последствия развития которых могут привести к потере органа. Наиболее опасно, если желчный камень закупорит желчевыводящие пути. В таком случае требуется экстренная медицинская помощь вплоть до удаления органа.
Кроме того, застойные процессы негативно влияют на пищеварительный процесс, поскольку дефицит желчи приводит к ухудшению расщепления тяжелых жиров, которые попадают в организм с едой. Как следствие, уровень концентрации жирных кислот растет, что мешает организму нормально утилизировать глюкозу. Как результат – сахарный диабет.
Не стоит забывать и о том, что вырабатываемая печенью желчь также отвечает за выведение из организма токсинов, образующихся в результате расщепления пищи (к примеру, билирубина). Если нормальное течение процесса выведения токсинов нарушено из-за недостатка желчи, уровень билирубина в крови растет, происходит общая интоксикация всего организма, растет нагрузка на печень и возникают внешние признаки желтухи.
Не до конца расщепленные липопротеины начинают быстро накапливаться в жировых отложениях, что приводит к быстрому набору веса. Вот почему ожирением страдают даже те люди, которые мало едят. Кроме того, нарушение нормального расщепления жиров опасно и тем, что это значительно ухудшает процесс усвоения организмом крайне необходимых ему витаминов (А, Е, Д, К), а это чревато появлением проблем со зрением, возникновением сердечно- сосудистых заболеваний, ухудшением состояния кожного и волосяного покровов и ускорением старения организма.
Причины
Состояние может быть вызвано различными факторами. Среди них выделяют врожденные и возникающие в процессе жизнедеятельности.
Деформация, причины которой носят приобретённый характер, зачастую вызвана:
- Хроническим холециститом. Представляет собой воспаление ЖП. Преимущественно возникает на фоне желчнокаменной болезни.
- Желчнокаменной болезнью. Представляет собой появление камней в желчном пузыре или его протоках.
- Несоблюдением принципов правильного питания или отсутствием режима приема пищи.
- Высокой интенсивностью физических нагрузок, направленной на переднюю стенку брюшины.
- Образованием спаек в тонкой кишке.
- Дистрофией диафрагмы.
- Патологиями и заболеваниями ЖКТ.
- Дискинезией желчевыводящих путей.
- Злокачественными опухолями или кистами.
- Инфекционными болезнями.
- Гельминтами.
Кроме того, патология может быть следствием поднятием тяжестей, перенапряжением или даже стрессовой ситуацией.
Врожденная деформация
Возникает из-за нарушения в ходе эмбрионального развития. Выделяют:
- По конфигурации органа: крюкообразную, S-образную, бычий рог, развитие перегородок и изгибов.
- Исходя из размера: гиперплазия (что означает деформацию вследствие чрезмерного увеличения) или недоразвитый ЖП.
- В зависимости от локализации: внутрипеченочную локализацию, расположение в средней линии брюшной полости, малом тазу и т. д.
В редких случаях обнаруживаются:
- Агенезия. При данной патологии ЖП отсутствует. Частично его деятельность осуществляет желчный проток
- Наличие второго ЖП. Крайне редкая патология, представляющая собой образование полости в желчном протоке, выполняющей схожие функции с ЖП.
- Удвоение долей. В полости образуется два ЖП, объединенных общим протоком.
- Дивертикул. Это аномальное выпячивание стенки органа и дефекты строения мышц ЖП.
Виды деформаций желчного пузыря
Лечение аномальных форм желчного пузыря у детей
Главной целью врачей становится нормализация процессов оттока желчи, купирование болевых синдромов и снятие воспалительных процессов. Важным условием скорейшего выздоровления является соблюдение постельного режима.
По мере исчезновения симптомов ребенок должен употреблять больше жидкости (за исключением газированных напитков, соков в тетрапаках). А питание должно носить строго диетический характер, список конкретных продуктов назначает лечащий врач (это могут быть молочные продукты, творог, определенные фрукты, нежирные бульоны, натуральные компоты из сухофруктов, паровые котлеты и прочее).
Если происходит возобновление болевых симптомов, во время приема пищи ребенок должен употреблять предписанные врачом обезболивающие препараты
Важно отметить, что в процессе лечения деформации желчного у детей и особенно новорожденных, не рекомендуется прием антибиотиков, желчегонных препаратов, витаминов групп С, В, А и Е. Если они и прописываются, то строго по назначению лечащего врача
В условиях стационара также применяются следующие методики лечения аномалии форм желчного:
- физиотерапия;
- дезинтоксикационная терапия;
- травяное лечение.
Лечение
Лечение деформации желчного пузыря подбирается в индивидуальном порядке после установления возможной причины патологии. Терапия должна быть комплексной и включать в себя как медикаментозное лечение, так и соблюдение диеты, отказ от вредных привычек. Если заболевание спровоцировано холециститом или другими проблемами с работой желчного пузыря, других органов пищеварительной системы, необходимо лечить первопричину.
Цель терапии заключается в том, чтобы устранить застойные процессы, нормализовать отток желчи, устранить болезненный синдром.
Если деформация ЖП является врожденной патологией, при этом у ребенка не возникают симптомы воспалительных процессов, нет проблем с пищеварением, то лечение не требуется. Однако на протяжении всей жизни ему необходимо следить за состоянием органа, регулярно делать УЗИ, чтобы вовремя распознать ухудшение.
Медикаментозное
Обычно назначаются такие группы лекарственных препаратов:
- Спазмолитики. Направлены на устранение болевого синдрома. Если пациент обратился к врачу или попал в больницу на скорой из-за острой боли в животе, области правого подреберья, сразу назначается эта лекарственная группа. К эффективным спазмолитикам относятся Но-шпа, Трамадол.
- Антибиотики. Назначаются для устранения воспалительного процесса, патогенных микроорганизмов. Обычно применяются препараты широкого спектра действия, типа Цефтриаксин.
- Пробиотики. Обязательны при применении антибиотиков, применяются для нормализации микрофлоры кишечника.
- Желчегонные средства. Часто составляют основу лечения, но только при условии отсутствия камней. К ним относятся Гепабене, Никодин, другие препараты.
- Витаминные комплексы. Одним из осложнений деформации желчного пузыря является снижение иммунитета, поэтому требуется применение этой лекарственной группы.
Для ускорения эффекта от применения спазмолитиков лучше вводить их внутривенно.
Народные средства
Народные средства эффективны только в качестве дополнения к медикаментозному лечению, также они могут применяться для профилактики заболеваний ЖП. Популярностью пользуются такие рецепты:
- Овес. На его основе готовят настой, для этого берем 500 г сухого растения, завариваем в 1 л кипятка, даем настояться, процеживаем. Принимаем по половине стакана трижды в день.
- Овощные соки. Это народное средство пользуется спросом из-за его доступности. Полезны соки из всех разрешенных по диете овощей, но наиболее полезными считаются картофельный, морковный, сельдереевый. В день рекомендуется принимать по стакану любого из них.
- Оливковое масло. Оно обладает желчегонным свойством, что ускоряет устранение воспалительного процесса. Рекомендуется принимать по 1 ст. л. масла утром натощак.
И также полезны рецепты на основе лекарственных растений: ромашки, мелиссы, чистотела, зверобоя, шалфея, пижмы, бессмертника, других.
Диета
Диета – важная часть лечения любых заболеваний желчного пузыря, в том числе его деформации. Основными принципами питания являются такие правила:
- кушайте небольшими порциями 4–6 раз в день;
- пища должна быть теплой, и горячее и холодное вредно для слизистой оболочки пузыря;
- все блюда готовятся на пару либо варятся, либо тушатся – жарить запрещено;
- не переедайте.
Категорически запрещены такие продукты:
- жирные, жареные, острые блюда;
- жирные сорта мяса и рыбы;
- консервы;
- колбасы, копчености;
- наваристые бульоны;
- мучное, сдоба;
- сладости;
- молочные продукты с высоким процентом жирности;
- газированные напитки, кофе, крепкий чай, алкоголь.
При наличии лишнего веса, от него важно избавиться, так как эта проблема является предрасполагающим фактором к деформации органа, диета поможет похудеть без вреда для организма.
В ежедневном рационе должны присутствовать отварные или тушеные овощи и фрукты, зелень, легкие бульоны, овощные пюре, вареное мясо, рыба. Из мучных изделий рекомендован ржаной или цельнозерновой хлеб. Заменить кофе, крепкий чай лучше на домашние компоты, морсы, отвар шиповника.
Таким образом, деформация желчного пузыря – это общее название различных изменений в структуре, форме, размерах органа. Точно диагностировать патологию можно по эхогенным признакам на УЗИ. Лечение должно быть комплексным, так как деформация может быть спровоцирована разными факторами, оно побирается в индивидуальном порядке. Обычно его основу составляет медикаментозная терапия и соблюдение диеты.
Симптомы перегиба желчного пузыря
УЗИ желчного пузыря
Если в организме происходит сбой, такой как перегиб желчного пузыря, симптомы которого будут описаны ниже, отток желчи нарушается, а желчь, как известно, довольно едкая и способная повредить любой орган, в том числе и сам желчный пузырь.
- Тошнота и рвота. Тошнота и рвота могут появляться периодически, особенно после обильного приема пищи. Опасный признак – постоянная тошнота и частая рвота. В этом случае можно говорить об угрозе жизни.
- Запоры. Нарушенное пищеварение и недостаточное поступление желчи в двеннадцатиперстную кишку приводят к тому, что кишечник не справляется со своей работой. Запоры при перегибе желчного пузыря неизбежны.
- Гастральный рефлюкс. Это болезненный и опасный синдром, суть которого заключается в том, что нарушается стандартная цепочка продвижения пищи. Из кишечника желчь с полупереваренными остатками пищи попадает в желудок, что вызывает боль, изжогу, тошноту, в некоторых случаях даже ожог слизистой желудка.
- Потливость. Повышенная потливость является проявлением общей ослабленности организма. При сильных болях также может выделяться холодный липкий пот.
- Вздутие живота. Выброс желчи в желудок и ее соприкосновение с кислотной средой, преобладающей в желудке, способствует повышенному газообразованию. У больного появляется ощущение вздутия живота, которое не проходит даже после посещения туалета.
- Боли в правом боку. Боль в животе бывает обычно ноющего характера. При попадании желчи в желудок может возникать чувство рези в животе.
- Горечь во рту. Присутствие желчи в желудке и даже пищеводе вызывает ощущение неприятной горечи во рту.
Лечение перегиба желчного пузыря в домашних условиях
В народной медицине издавна используются рецепты отваров и настоек из различных природных и натуральных ингредиентов для лечения болезней желчного пузыря, в частности, и такой патологии, как перегиб.
Все эти рецепты могут сопровождать лечение и способствовать выздоровлению, либо оказывать отличный профилактический эффект.
Рецепты отваров и настоек с желчегонным эффектом
Сбор лекарственных трав. Для приготовления измельченные ингредиенты смешиваем в пропорциях: 2 чайные ложки листьев мяты, 2 чайные ложки цветков бессмертника, 4 ложки цветков ромашки, 4 ложки вахты трехлистной и одуванчика лекарственного, 5 ложек травы зверобоя. Этот сбор можно приготовить вручную, или купить в аптеке, как желчегонный сбор. Одну чайную ложку сбора заливают 500 мл кипяченой воды и оставляют настаиваться на 30 минут в защищенное от солнца место. Отфильтрованное снадобье употребляют 3 раза в день по 200 мл перед приемом пищи.
- Настой календулы. Цветы календулы в размере 1 столовой ложки заливаются 200 мл кипяченой воды. Готовый настой употребляют трижды в день по 50 мл. Календула знаменита отличным желчегонным эффектом, а также она применяется при лечении воспаления желчного пузыря.
- Расторопша. Плоды этого растения употребляются в сыром и измельченном виде в объеме 15 г перед употреблением пищи, обязательно запиваются водой. Также измельченные плоды расторопши добавляют в овсяную кашу, ряженку, кефир, что облегчает и делает незаметным их употребление.
- Кукурузные рыльца. Употребляются в виде настойки на воде, или спиртовой настойки. Для приготовления настоя в домашних условиях берут одну столовую ложку измельченной и сухой травы, и заливают 200 мл кипяченной воды. Готовый и отфильтрованный настой пьют за полчаса до приема пищи по 50 г трижды в день. Также можно применять спиртовой настой кукурузных рылец, который можно купить в аптеке. На 150 мл воды понадобится 35 капель спиртовой настойки. Принимается также, как и настойка на воде: до приема пищи, 3 раза в день. Экстракт кукурузных рылец снимает неприятные проявления перегиба желчного пузыря, такие, как чувство тошноты, боли в подреберье.
- Шиповник. Отвар шиповника, в сравнении с другими желчегонными рецептами настоек, более приятный на вкус, и оказывает мягкое, щадящее действие.
- Благоприятно действует на желудок и кишечник, улучшая функционирование желудочно-кишечного тракта. Для приготовления настоя лучше использовать спелые, высушенные и измельченные плоды шиповника в объеме 2 столовых ложек, залить 200 мл кипяченой воды и настоять несколько часов. Употребляется отфильтрованный настой трижды в день перед каждым основным приемом пищи по 100 мл.
- Зверобой. Это, без преувеличения, целительное растение можно применять не только в составе желчегонного сбора, но как отдельный, самостоятельный элемент лечения. Для приготовления отвара нужно одну столовую ложку сухого растения залить 200 мл кипяченой воды и подогреть на небольшом огне еще 10-15 минут. Остывший и отфильтрованный отвар употреблять по 50 мл перед употреблением еды (утром, в обед, вечером). Применяется также при лечении холецистита.
Лечебная гимнастика при перегибе
Специальные физические упражнения могут облегчить болезненные симптомы и предотвратить усугубление патологии. Желательно, если лечебная гимнастика будет обговорена с вашим лечащим врачом, а его разрешение на применение физиопроцедур – обязательно.
Первое упражнение
Исходное положение: лежа на животе, корпус строго параллелен полу, руки вдоль тела, пальцы ног упираются в пол. Во время глубокого выдоха туловище отрывается от пола, начиная с головы, далее грудная клетка, упор переходит на руки, спина прогнута. На этом моменте нужно задержать позу на 3-4 секунды, не задерживая дыхание. Далее плавно возвращаемся к изначальному положению. Повторить 5 раз.
Второе упражнение
Исходное положение: на спине лежа, руки подняты над головой и параллельны полу, спина прямая и зафиксирована. На плавном выдохе поднять ноги на 30 градусов от пола, зафиксировать позу на несколько секунд; далее перенести с этой позы прямые ноги на 50 градусов от пола, зафиксировать на 4-5 секунд. Выдыхая, ноги плавно опустить вниз и полностью расслабить тело. 4 повторения
Во время выполнения упражнений важно не задерживать дыхание: нужно дышать очень плавно и медленно
Третье упражнение
Исходное положение: стоя в полусогнутой позе или лежа на спине, с вытянутыми вдоль тела руками. Упражнение по типу «вакуум». Очень глубоко вдохнув, задержать дыхание на 3-4 секунды. Далее плавно выдыхать воздух, напрягая мышцы пресса.
Данные упражнения будут полезны также для профилактики и лечения поясничного радикулита.
Источник
Лечение перегиба желчного пузыря
Если врожденный перегиб желчного пузыря ничем себя не выдает, то человек может прожить с ним всю жизнь и обнаружить патологии случайно – при УЗ-обследовании по совершенно другому поводу. В таких случаях лечение перегиба желчного пузыря не проводится. Тем более что само лечение направлено не на причину, а на симптомы.
При наличии признаков и подтверждении диагноза лечение перегиба желчного пузыря включает прием лекарственных препаратов и соблюдение щадящей диеты.
Гастроэнтерологи чаще всего назначают желчегонные при перегибе желчного пузыря.
Препарат Фламин в форме таблеток применяется как желчегонное средство при многих патологиях желчного пузыря. Его действующее вещество – очищенные полифенольные флавоноиды и гликозиды лекарственного растения бессмертник песчаный. Назначается по одной таблетке (0,05 г) трижды в день – день за 30 минут до приема пищи, запивая 100 мл теплой кипяченой воды. Детям 3-7 лет следует принимать по полтаблетки три раза в день, детям 7-12 лет – по три четверти таблетки, старше 12 лет – дозировка как взрослым. Курс лечения составляет от 10 до 40 дней (определяется лечащим врачом с учетом степени выраженности симптомов перегиба желчного пузыря).
Желчегонное средство Одестон (синонимы – Химекромон, Кантабилин, Адесин Ц, Холестил, Гимекромон) не только ускоряется эвакуацию желчи в просвет кишечника, но и снимает спазм желчных протоков. Данный препарат назначается в дозировке: по одной таблетке (0,2 г) три раза в день за полчаса до еды. Длительность курса терапии – две недели. Применение Одестона может вызвать побочные действия: диарею, крапивницу, головные боли и боли в эпигастральной области, изъязвления ЖКТ и метеоризм. Противопоказаниями к применению данного препарата являются: детский возраст, беременность и лактация, печеночная и почечная недостаточность, обструкции желчного пузыря, язвенные заболевания ЖКТ, болезнь Крона, гемофилия.
Комбинированный препарат Аристохол (спиртовой экстракт во флаконах) содержит спиртовые экстракты травы тысячелистника, чистотела, полыни, корней одуванчика, плодов кошачьих лапок и чертополоха. Их суммарное действие направлено на опорожнение желчного пузыря и снятие спазмов. Кроме того, при запорах аристохол действует как послабляющее. Назначается только взрослым – по 20-25 капель в небольшом количестве воды 2-3 раза в день (после приема пищи).
Препарат Хофитол при перегибе желчного пузыря, обладающий желчегонным и гепатопротекторным действием и часто назначается при лечении данной патологии у детей. Активным компонентом данного лекарственного средства является сухой водный экстракт из листьев артишока полевого. Таблетки хофитол принимают взрослые и дети старше 12 лет – по 1-2 таблетке трижды в день (перед едой); дети 6-12 лет – по одной таблетке. Курс лечения – 2-3 недели.
Хофитол в форме раствора назначают внутрь по 2,5-3 мл трижды в день (перед приемом пищи); детям до 12 лет назначается четверть или половину взрослой дозы (как назначит врач). Побочный эффект при длительном приеме этого препарата выражается диареей. А среди противопоказаний значатся: обтурация желчных путей, острые воспалительные заболевания почек, печени и желчевыводящих путей, печеночная недостаточность, а также наличие камней в желчном пузыре.
Снять симптомы перегиба желчного пузыря помогает синтетическое желчегонное средство Циквалон (синонимы – Бевено, Флавугал, Ванилон, Диванил, Диванон) в форме таблеток по 0,1 г. Его врачи назначают по 0,3 г в день (3 таблетки) в первые два дня лечения. Затем принимается по таблетке 4 раза в течение суток. Курс лечения длится 3-4 недели. Перед повторным курсом обязательно делается перерыв на 30 дней.
Противопоказаниями Циквалона являются индивидуальная гиперчувствительность, острый гепатит, закупорка желчных протоков, язвенная болезнь желудка и двенадцатиперстной кишки, цирроз печени. Среди побочных эффектов отмечаются чувство давления в области печени и желчного пузыря и усиление горечи во рту.
Особенности питания
Основной задачей при данном нарушении является обеспечение свободного пищеварения. Диета предполагает употребление легкоусвояемой пищи в теплом виде маленькими порциями. Питание может основываться на принципах, приведенных в таблице.
| Наименование | Рекомендуется к употреблению | Запрещено |
|---|---|---|
| Закуски | Консервированные, соленые, маринованные овощи; колбасные пряные изделия; острые сорта сыров. | |
| 1 блюда | Супы-пюре; легкие бульоны; крупяные и овощные супы. | Наваристые первые блюда; острые и жирные блюда. |
| Мясо | Мясо с низкой жирностью, вареное, рубленное, приготовленное на пару. | |
| Рыба | Нежирная рыба в отварном виде или на пару. | Копченная, соленая или вяленая; жирная рыба. |
| Молочные продукты | Молоко менее 2,5 процентов жирности, обезжиренные кисломолочные продукты. | Сливки и другие продукты с высокой долей жирности. |
| Овощи и фрукты | Преимущественно в отварном и припущенном виде, также приготовленные на пару. Сухофрукты и запеченные плоды. | Острые и пряные овощи (лук, чеснок, хрен, редис), кислые плоды. |
| Мучные изделия и хлеб | Преимущественно ржаной или цельно-зерновой, подсушенный. | Свежие хлебобулочные изделия, сладкие кондитерские изделия. |
| Напитки | Домашние некислые компоты, морсы, некрепкие чаи. | Крепкий кофе/чай, алкоголь, газированные напитки. |
Диагностика перегиба желчного пузыря
Главный метод, с помощью которого осуществляется диагностика перегиба желчного пузыря – ультразвуковое исследование (синонимы – эхография, сонография). УЗИ дает возможность не только определить функциональное состояние органа и точную локализацию патологии, но и обследовать его стенки, зоны шейки и протока.
Как отмечают специалисты, выяснить причины перегиба желчного пузыря при его УЗ-исследовании не так просто. Чтобы определить характер патологии (врожденный или приобретенный), УЗИ сначала делается до, а затем после приема яичных желтков, вызывающих повышенную секрецию желчи. Когда перегиб желчного пузыря врожденный, то деформация органа остается без изменений.
Эхопризнаки перегиба желчного пузыря (или эхографические симптомы) при продольном и поперечном сканировании органа на аппарате линейного типа выражаются в том, что на изображении четко просматривается изменение нормальной формы органа в виде эхопозитивных линейных образований различной локализации. Чаще всего перегиб фиксируется в месте перехода тела пузыря в шейку. При этом желчь, находящаяся в пузыре, имеет вид эхонегативного образования.
Кроме того, в ходе исследования моторики желчного пузыря выясняется наличие и степень дискинезии желчевыводящих путей, которая бывает в 80% случаев диагностики перегиба желчного пузыря.
Искажение, носящее приобретенный характер
Возникновение перегибов может наблюдаться в различных областях органа, но обычно встречаются изменения шейки. Наиболее тяжелым принято считать перегиб тела. Подобные отклонения вызывают нарушение отхода желчи, что в конечно счете приводит к желчнокаменной болезни. Помимо всего прочего, в кишечник не попадает нужный объем желчи. Вследствие этого жиры расщепляется не полностью, кровь насыщается жирными кислотами, а активность окисления глюкозы падает.
Неправильное высасывание жиров вызывает дефицит жирорастворимых витаминов. Организм не дополучает материал, требуемый для энергетических запасов. Это все оказывает влияние на сократительную функцию мышц, снижает эластичность сосудов и даже остроту зрения.
https://youtube.com/watch?v=aQblrANr9CY
Затяжка желчного пузыря создает предпосылки для появления холецистита в хронической форме. Механические затруднения отделения желчи увеличивают количество билирубина, что в свою очередь вызывает появление желтухи.
При загибании желчного пузыря выявляют нарушение кровоснабжения. Результатом этого становятся отмершие клетки и трещины, по которым желчь находить путь в полость брюшины. В этой ситуации у человека вполне может развиться желчный перитонит.
Изменение привычного состояния желчного пузыря может нанести отрицательное влияние весь организм в целом.
Симптомы
Начальными признаками, говорящими о перегибе пузыря являются рвотные позывы, тошнота, ощущение горечи, дискомфорт в желудке после приема пищи. Для пациента такие явления достаточно часто становятся обыденными. Подъем температуры, упадок сил, боли во всем животе говорят о том, что кровообращение нарушено и появились трещины, через которые желчь и находит свой путь наружу. Подобные симптомы могут говорить о перфорации желчного пузыря. В этом случае не следует затягивать с походом к врачам.
Компьютерная томография (КТ) желчного пузыря
Каловые массы светлого оттенка и темная моча указывают на то, что в кишечник не попадает желчь. Если загиб произошел вследствие резкого движения или физической работы, то проявления могут отсутствовать вовсе. Человек может узнать об имеющихся отклонениях только при проведении планового осмотра. Патологии могут протекать скрытно, но организм все равно стоит поберечь, соблюдая диету.
Лечение
При появлении каких-либо отклонений от нормального состояния, будьте готов к долгой терапии медикаментами. Вначале выписывают желчегонные медикаменты (Никодин, Фламин, Гепабене и другие). Их принимают на протяжении полугода ежемесячно по две недели. Медиками могут выписываться спазмолитики. При признаках острого холецистита принимают антибиотики. Они облегчают протекание болезненного состояния.
В качестве дополнительных мер можно воспользоваться цветочной пыльцой, пергой и кукурузным маслом. Физиотерапия (аппликации парафина, электрофорез с новокаином) также дает положительный эффект. Пациент должно соблюдать умеренность в физических нагрузках, а также держать диету. В более запущенныз случаях желчный пузырь приходится удалять.
Природная форма
Подобные состояния появляются также и во время развития в утробе матери. Причины этих аномалий могут скрываться в различных пагубных процессах:
- неблагоприятная окружающая среда;
- хронические болезни или вредные привычки;
- применение лекарственных препаратов;
- генетические сбои.
Иногда патологии никоим образом не проявляют себя, поэтому в лечении нет необходимости. Значительные осложнения, к примеру, множественные загибы, оказывают влияние на физическое развитие ребенка и выделение желчи.
Классификация
По форме:
- бычий рог;
- в виду буквы S;
- перегородки;
- крючкоидная;
По размерам:
| № | Полезная информация |
|---|---|
| 1 | орган может быть недоразвитым |
| 2 | vesica fellea слишком больших размеров |
По местонахождению:
- внутри печени. Пузырь закрепляется в паренхиме. Клинически такое состояние не заметно, но по мере взросления видна высокая склонность к желчнокаменному заболеванию;
- дистопия. Пузырь располагается в правой подвздошной области или же в малом тазе;
- ротация. Желчный может обладать иными направлениями продольной оси;
- интерпозиция. Явление такого толка наблюдается достаточно редко. Его ооличительной чертой является отсутствие печеночного протока.
Аномалии
Агенезия. Не частое осложнением, при котором можно наблюдать полное отсутствие желчного пузыря. При этом варианте желчный проток начинает играть накопительное предназначение. Он расширяется и выполняет роль сосуда для желчи.
https://youtube.com/watch?v=Y6AEZiaKIWI
По имеющимся статистическим данным, можно смело говорить о том, что врожденная аномалия диагностируется чаще у девочек. Заболевание у малышей протекает без каких-либо признаков. У детей постарше может диагностироваться воспаление желчных проходов, холелитиаз, а также нарушение моторики желчевыводящих путей.
Данную патологию выявляют при проведении рентгенологического исследования. На полученном изображении можно разглядеть, что общий желчный проток расширяется, а тени от желчного пузыря нет вовсе.
Дополнительный желчный пузырь. Редкое явление. В желчных протоках появляется полость, из которой создается еще один орган, имеющий отдельный пузырный проток.
Двудольный Vesica fellea. Зачаток желчного пузыря удваивается у эмбриона, формируется пара органов с одним протоком.
Врожденный дивертикул – явление, при котором стенка выпячивается, а мышечный слой пузыря видоизменяется. Первые несколько лет такая патология никак себя не выдает. Но сокращение дивертикула происходит медленнее, нежели пузыря. В будущем в области выпячивания начинает скапливаться желчь, что вызывает воспалительное явление и образование камней.
Патология в конечном итоге вызывает развитие калькулезного холецистита. В раннем возрасте деформирование желчного пузыря незаметна. Какие-либо аномалии могут быть обнаружены уже более зрелом возрасте. Из-за нарушенного оттока желчи создаются идеальные условия для появления камней. Выбор способа лечения полностью зависит от патологии.
Что именно приводит к деформациям?
С желчным пузырем в процессе жизни случаются изменения.
Принято выделять следующие причины, по которым случается деформация:
- органы брюшной полости опускаются;
- холецистит хронической стадии;
- постоянные нагрузки;
- желчнокаменная болезнь;
- новообразования;
- появление спаек;
- хронические болезненные состояния желудка и двенадцатиперстной кишки;
- воспаление стенок;
- несбалансированный рацион;
- паразитарные, инфекционные состояния;
- травмы брюшины.
Трудноусвояемая и жирная еда стимулирует секрецию желчи, перегружая тем самым пузырь.
Питание при деформации желчного пузыря
Питание при деформации желчного пузыря можно доступно описать в таблице:
|
Разрешено |
Нельзя |
|
|
Хлебобулочные изделия. |
Хлеб из темного сорта муки, желательно позавчерашней выпечки или присушенный, макаронные изделия. |
Хлеб свежей выпечки, сдоба, слойки, обжаренное тесто, блинчики, пироги, торт. |
|
Первые блюда. |
Перетертые супы из крупяных изделий и овощей, без мяса, желтков и зеленых побегов лука, без зажарки. |
Мясной, грибной и рыбный бульоны. |
|
Закуски. |
Овощи или фруктовые салаты, винегрет, протушенные овощи, молочная диетическая колбаса, малоострые и маложирные сыры. |
Соленья, острое и жирное, консервированные продукты, копчености, икра. |
|
Мясные продукты. |
Маложирное перетертое отварное или на пару мясо, можно в виде голубцов, тефтелек в пароварке. |
Жирные части мяса и сало, субпродукты. |
|
Рыбная продукция. |
Нежирные виды рыбы в отварном и пропеченном виде. |
Жирные рыбные блюда, а также обжаренная, копченая и засоленная. |
|
Яйца. |
Паровой белковый омлет. |
Желток, яичница. |
|
Молокопродукты. |
Свежее молоко до 2,5% жирности, простокваша, кефир, нежирная сметана, обезжиренный творог. |
Сливки, жирные молокопродукты. |
|
Крупы и макароны. |
Любые. |
|
|
Овощи. |
Практически все. |
Щавель, редис, зеленый лук, чеснок, овощи в маринаде. |
|
Бобовые. |
Зеленый горошек в виде пюре. |
Фасоль, чечевица, горох. |
|
Фруктовые и ягодные блюда. |
Некислые, в свежем, отварном и запеченном виде, а также сухофрукты. |
Кислые фрукты и ягоды. |
|
Десерты. |
Кисель, компот, суфле, желе, мармелад, зефир, мед, домашнее варенье. |
Изделия с шоколадом, кремом. Мороженое. |
|
Масла. |
Сливочное масло в небольших количествах, растительное рафинированное масло. |
Тугоплавкий жир, сало. |
|
Напитки. |
Некрепкий чай и кофе с добавлением молока, компот, свежевыжатый сок. |
Холодные напитки, газировка, растворимый кофе, какао. |
|
Специи и соусы. |
Соус домашнего приготовления на сметане, молоке, овощном бульоне. Фруктовые сиропы. Зелень, ванилин, корица. |
Острые специи, промышленные майонез, кетчуп. |
[]